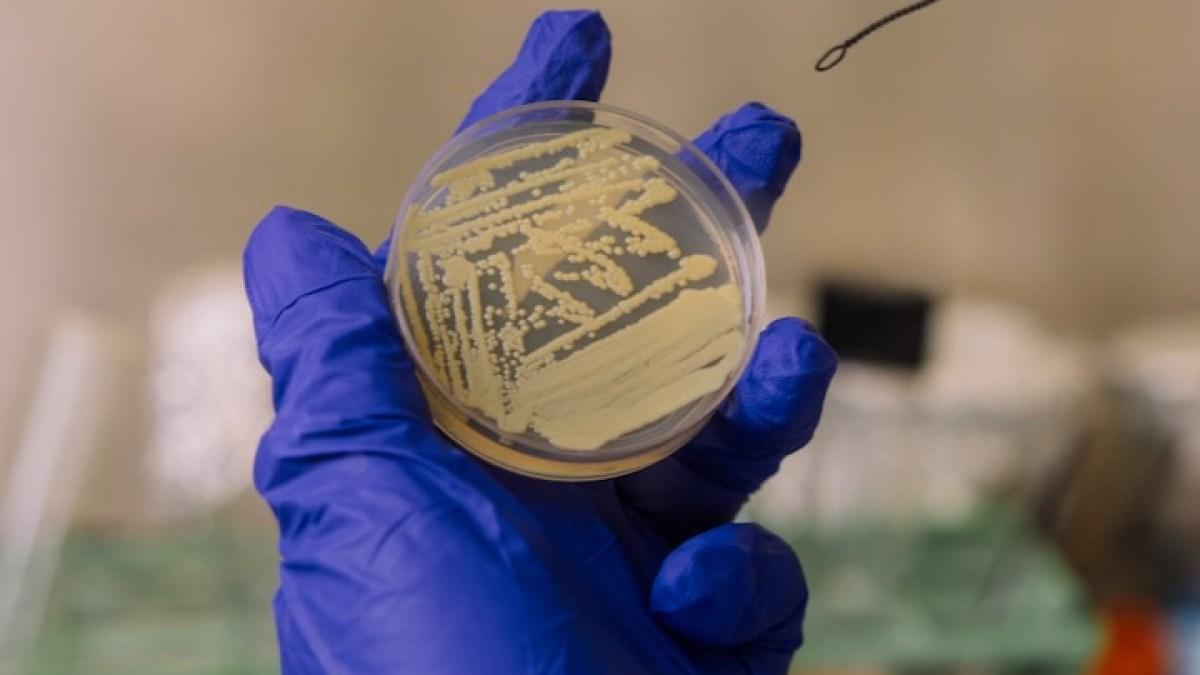
بكتيريا في مختبرات ناسا تتظاهر بالموت! بكتيريا في مختبرات ناسا تتظاهر بالموت!

أفريقيا برس – السودان. في أقصى زوايا غرف التعقيم التابعة لوكالة ناسا، حيث لا يسمح حتى لذرة غبار واحدة بالبقاء، كان هناك كائن مجهري يراقب في صمت. لم يكن يتحرك، لم يكن ينمو، ولم يظهر أي دليل على الحياة. ظن العلماء أنه ميت. لكنه لم يكن كذلك. لقد كان يتظاهر بالموت.
هذا ما اكتشفه فريق من علماء الأحياء الدقيقة في جامعة هيوستن، عندما وجد أن نوعا غامضا من البكتيريا معروفا باسم “تيرسيكوكوس فونيسيس”، استطاع الإفلات من أقسى إجراءات التعقيم، مما أثار دهشتهم ودفعهم إلى التساؤل: كيف تمكن هذا الكائن الدقيق من النجاة في أكثر البيئات نظافة على الأرض؟
وفي دراسة حديثة نُشرت في مجلة “ميكروبيولوجي سبكتروم”، كشف العلماء سر هذا “الكائن المتخفي” بعد أكثر من عقد من الزمن على الإعلان عن اكتشافه لأول مرة في غرف التجميع المعقمة للمركبات الفضائية، وهي بيئات تخضع لإجراءات تنظيف صارمة تهدف إلى منع أي شكل من أشكال التلوث الميكروبي.
بيئات التعقيم لا تخلو من الحياة
عندما تُبنى مركبة فضائية، لا يكفي أن تكون دقيقة التصميم فحسب، بل يجب أن تُصنع في بيئة تكاد تكون خالية من أي شكل من أشكال الحياة الميكروبية.
يقول الدكتور مادها تيرومالاي، أستاذ علم الأحياء الدقيقة في جامعة هيوستن وأحد المشاركين في الدراسة في تصريحات للجزيرة نت، “هذه المركبات يُفترض أن تكون أقرب ما يمكن إلى بيئات خالية تمامًا من أي أثر ميكروبي، ولا سيما عندما تكون مهمتها الأساسية هي البحث عن الحياة على عوالم أخرى”.
لهذا تُصمم غرف خاصة فائقة التعقيم عادة ما تعرف بـ”غرف التنظيف الفائق”، وهي من أكثر البيئات تعقيما على الأرض، وتُستخدم فيها تقنيات متقدمة للحفاظ على نقاء الهواء والأسطح.
في هذه الغرف، تُستخدم مرشحات هواء متقدمة لتقليل الغبار والملوثات، وضغوط هوائية موجهة نحو الخارج، وأشعة فوق بنفسجية، وغازات قاتلة للميكروبات، وحتى الحرارة الجافة التي تتجاوز درجة غليان الماء لتدمير أي أثر للحياة.
ومع كل ذلك، لا تزال بعض الميكروبات قادرة على النجاة. فحتى في غياب أي مصدر غذاء تقريبا، وتحت أشد الظروف قسوة، تستطيع بعض الكائنات المجهرية البقاء بطرق مذهلة.
وقد كشفت عمليات المسح الميكروبي التي تجريها ناسا ووكالة الفضاء الأوروبية بانتظام عن مئات الأنواع البكتيرية، كثير منها لم يكن معروفا للعلم من قبل، بل إن بعضها عُثر عليه حتى على سطح محطة الفضاء الدولية، حيث الظروف القاسية من إشعاع وبرودة وفراغ فضائي.
وقبل أكثر من 10 سنوات، اكتشف العلماء بكتيريا تيرسيكوكوس فونيسيس التي تسللت إلى غرف التجميع الفضائية الخاصة بوكالة ناسا، لكن المفاجأة أن هذه البكتيريا لم تُكتشف في غرفة واحدة فقط، بل في غرفتين تفصل بينهما آلاف الكيلومترات، إحداهما في مركز كينيدي الفضائي التابع لناسا في فلوريدا، والأخرى في غرفة تابعة لوكالة الفضاء الأوروبية في غويانا الفرنسية.
لاحقا تبين أن تلك البكتيريا غير ضارة بالبشر، لكنها أثارت حيرة وقلق العلماء لأنها تمكنت من البقاء فترة طويلة داخل بيئة يُفترض أنها خالية تماما من الحياة، دون أن تُكتشف أو تتأثر بعمليات التعقيم الصارمة.
البكتيريا التي تتقن “التظاهر بالموت”
بعض هذه الميكروبات المكتشفة ينجو عبر استهلاك مواد التنظيف نفسها، في حين يحتمي البعض الآخر داخل أبواغ سميكة الجدار، قادرة على البقاء خاملة لملايين السنين حتى تتوفر ظروف مناسبة للنمو من جديد.
أما تيرسيكوكوس فونيسيس فلا تكوّن أبواغا ولا تظهر أي تغير شكلي للحماية، بل تلجأ إلى حيلة مختلفة تمامًا، وهي الكُمُون الصامت. فحين تُحرم من الماء والعناصر الغذائية، تدخل في حالة سبات عميق أشبه بالبيات الشتوي، أي حالة خمول تامة تتوقف فيها كل أنشطتها الحيوية تقريبا، مما يجعلها غير قابلة للكشف بالطرق التقليدية، لكنها تبقى على قيد الحياة، تنتظر فقط اللحظة المناسبة لتستيقظ من جديد.
عند دراسة الجينوم الخاص بهذه البكتيريا، لاحظ الباحثون أنها تحمل جينا لإنتاج بروتين يُعرف باسم عامل تنشيط الإحياء، وهو بروتين قادر على “إيقاظ” بكتيريا أخرى من حالتها الساكنة، لكن وجود الجين لا يعني بالضرورة أن البكتيريا تستخدمه، لذا قرر فريق تيرومالاي إجراء تجربة حاسمة.
قام الباحثون بحرمان البكتيريا من الغذاء والماء حتى وصلت إلى درجة الجفاف التام، فدخلت في سبات عميق. وعندما حاولوا إعادة إيقاظها بإضافة الغذاء، لم تستجب فورا، بل بقيت ساكنة لعدة أيام. بدا الأمر كما لو أنها ماتت.
يقول تيرومالاي “إنها ليست ميتة. إنها فقط تلعب دور الميت. لإثبات أنها كانت نائمة فقط، أضفنا بروتين عامل الإنعاش من بكتيريا قريبة، فاستيقظت الخلايا فورا، وبدأت تنمو مجددا، وهو ما أكد أنها كانت ببساطة تتظاهر بالموت”.
هذا البروتين لا يوجد طبيعيا في غرف التعقيم، لكنه يُفرَز من قبل بكتيريا شائعة تعيش على جلد الإنسان، وهذا يعني أنه في أي بيئة مأهولة بالبشر، يمكن لتيرسيكوكوس فونيسيس أن تستيقظ بسهولة وتبدأ بالنشاط من جديد.
تهديد يتجاوز حدود الأرض
عُثر على تيرسيكوكوس فونيسيس لأول مرة عام 2007، عندما أخذ مهندسو ناسا عينات من أرضية غرفة تجميع مركبة “فينيكس” في مركز كينيدي للفضاء بفلوريدا، أثناء تحضيرها للانطلاق نحو المريخ.
ومع أن فرص بقائها على سطح الكوكب الأحمر شبه معدومة، نظرًا للإشعاع الشمسي القوي والبرد القارس والظروف الجافة، فإن اكتشافها أثار تساؤلات حول إمكانية تلوث الكواكب الأخرى بالكائنات الأرضية، وهو ما يُعرف بـ”مبدأ الحماية الكوكبية”.
يقول تيرومالاي “تكشف هذه البكتيريا عن تحديات عميقة تتعلق بحماية الكواكب، أي منع انتقال الحياة الأرضية إلى عوالم أخرى، فإذا صعدت خلية نائمة إلى مركبة فضائية دون اكتشافها، فقد تنجو من الرحلة، وتستيقظ لاحقا على كوكب مثل المريخ”.
ويضيف “هذا قد يؤدي إلى تلويث البيئات الأخرى بكائنات من الأرض، وإرباك الأبحاث التي تبحث عن حياة خارجية، فقد يلتقط العلماء إشارة حياة مصدرها الأرض لا المريخ، وتشكيل مخاطر على البعثات المأهولة، إذ قد تستيقظ مثل هذه البكتيريا داخل الموائل البشرية أو تؤثر في المواد أو الأنظمة الحيوية”.
الأمر لا يقل أهمية عندما يتعلق بحماية رواد الفضاء أنفسهم من الميكروبات الضارة خلال الرحلات الطويلة، ففي مهمات مأهولة إلى محطة الفضاء الدولية أو إلى القمر أو حتى إلى المريخ، قد تشكل هذه الكائنات خطرا على الأنظمة أو المواد أو صحة الرواد، فضلا عن احتمالية تلويث مواقع البحث بكائنات أرضية أو اختلاط كائن أرضي مجهري بآخر محتمل من عوالم أخرى.
يقول تيرومالاي “تشير نتائجنا إلى أن السبات قد يكون أكثر شيوعًا في غرف التجميع الفضائية مما نعتقد. لذا، فإن تحديث أدوات الكشف وطرق التنظيف سيكون ضروريا للحفاظ على نقاء البيئات الكوكبية، ولضمان ألا تُفسر ميكروبات أرضية نائمة على أنها “حياة مريخية”.
ويشير الباحثون إلى أن هذا الاكتشاف لا يهم وكالات الفضاء فحسب، بل له انعكاسات واسعة على قطاعات حيوية أخرى، مثل غرف العمليات الطبية، ومختبرات صناعة الأدوية، ومنشآت إعداد الأغذية وحتى المستشفيات، وجميعها قد تخفي بكتيريا نائمة غير قابلة للكشف بالطرق التقليدية.
لكن إذا كانت بكتيريا غير ممرضة مثل تيرسيكوكوس فونيسيس قادرة على الاختباء في بيئات معقمة بهذه الدقة، فماذا عن الأنواع الممرضة التي قد تمتلك القدرات ذاتها؟
لهذا السبب، يقترح العلماء تكثيف البحث عن آثار الحمض النووي في الأسطح المعقمة، للكشف عن البكتيريا النائمة حتى في غياب نشاطها الظاهري.
كما يقترح البعض منعها من الدخول في السبات أصلا، عبر تحفيزها على الاستيقاظ ببروتين “عامل الإنعاش”، ثم القضاء عليها بالمضادات الحيوية المعتادة.
ورغم أن الرحلات القصيرة إلى محطة الفضاء الدولية لا تبدو مهددة بعد، فإن البعثات الطويلة إلى القمر أو المريخ ستحتاج إلى إجراءات أعقد وأكثر ذكاء، خصوصا مع ما يعرف بتأثير الفضاء على ضع.ف جهاز المناعة لدى رواد الفضاء، مما قد يزيد من خطر أي عدوى غير متوقعة.